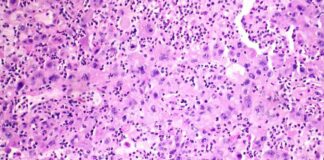
David Epstein launches new cancer startup after Novartis and Seagen career news-28102024-163033

Tag: Bone and skin disorder
Rare Disease Research: NIH Findings on Bones, Skin, & Endocrine System
Fibrous dysplasia/McCune-Albright Syndrome is a rare genetic disease that affects bones, skin, and the endocrine system. Patients with this condition may experience fractures, early puberty, vision and hearing loss, and other complications. While there...
Decades of NIH Research Reveals Insights on Rare Bone, Skin, and Endocrine Disorder
Decades of NIH Research Reveals Insights on Rare Bone, Skin, and Endocrine DisorderPatients with fibrous dysplasia/McCune-Albright Syndrome often face challenges such as easily breaking bones, early puberty, and potential vision and hearing loss. For...